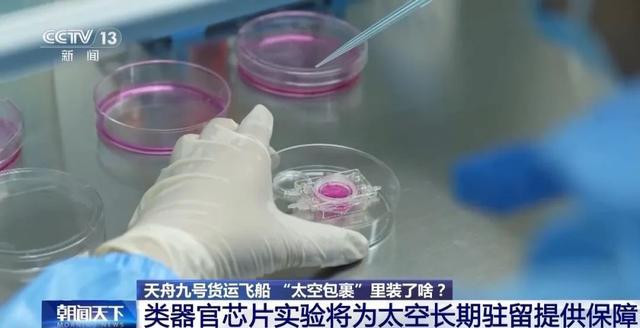

据中国载人航天工程办公室消息,北京时间2025年7月15日5时34分,搭载天舟九号货运飞船的长征七号遥十运载火箭,在我国文昌航天发射场点火发射,约10分钟后,天舟九号货运飞船与火箭成功分离并进入预定轨道,之后飞船太阳能帆板顺利展开,发射取得圆满成功。天舟九号货运飞船入轨后顺利完成状态设置,于北京时间2025年7月15日8时52分,成功对接于空间站天和核心舱后向端口。
不断创新优化工艺
航天食谱上新
这次天舟九号运送的物资中,航天食品占了不小的比重,而且航天员的太空菜谱上也有了新菜品。
中国航天员科研训练中心刘微:天舟九号货运飞船上行的航天食品的总量超过了1.5吨,种类也达到了190多种,其中副食增加了20多种,现在副食已经达到了90多种。

据介绍,增加的菜品里包括了麻婆豆腐、番茄鸡蛋、清炖马蹄、素三鲜、小炒莲藕、外婆菜、孜然土豆等,别看这些都是咱们老百姓餐桌上的家常菜,要想把它们加进航天员的太空菜谱里,可就需要地面科技人员大量的研究攻关了。
中国航天员科研训练中心刘微:比如麻婆豆腐这个产品,我们平时在家里烹饪的时候都要小心翻炒,因为很容易破坏它的形状和质构。但是这次通过技术攻关和工艺改进,我们也成功地将麻婆豆腐送上了航天员的太空餐桌。

研究人员不断创新和优化航天食品的生产工艺,最大限度保持菜品原有的质构、色泽、风味和营养,送越来越多的菜肴上太空。
中国航天员科研训练中心刘微:实现了航天食品从最初的一口式、牙膏式食品,到现在的主食、副食、即食、调味品,甚至新鲜果蔬,我们叫作“三食四品”的突破。

航天员队伍不断壮大,航天员口味也不尽相同。更多菜系也开始纳入航天食品的整体设计中。

中国航天员科研训练中心刘微:其实很多人都会问航天食品到底是什么,是不是都是我们没有见过、没有吃过的东西。恰恰相反,其实我们航天人追求的就是让航天员在太空餐桌上能和所有普通的人在家里一样,能够品尝到人间烟火气。
空间实验将找寻
克服肌肉萎缩的新途径
这次随天舟九号还上行了23项科学实验物资,总重量近780公斤。人体内有600多块肌肉,大概占到人体体重的40%,肌肉的健康对于人类的健康十分重要。在太空环境下,人的肌肉会出现萎缩。在即将开展的空间微重力环境对骨骼肌前体细胞迁移的影响及其机制的空间科学实验中,就将在微重力环境下来找寻克服肌肉萎缩的新途径。
据了解,空间微重力环境下出现的肌肉萎缩与在地面因年龄增长而导致的肌肉萎缩情形十分相似。负责相关实验项目的科研团队这次重点关注骨骼肌前体细胞在微重力条件下,在细胞培养单元里面是如何迁移的,希望通过研究微重力对骨骼肌干细胞的影响,来揭示空间环境是怎么导致肌肉萎缩的分子机制,找到关键的调控因子,从而为抵抗肌肉萎缩找到新的应对策略。

中国科学院上海营养与健康研究所研究员应浩:在骨骼肌的细胞稳态发生紊乱的时候,就会发生肌肉萎缩。在正常情况下,骨骼肌中有一类细胞叫骨骼肌的前体细胞或者说它的干细胞,它可以通过增殖分化来修复损伤的肌肉或者恢复骨骼肌的稳态,从而维持正常的运动和代谢功能。所以,研究骨骼肌干细胞对于怎么维持健康的肌肉是非常重要的,把这个过程研究清楚以后,就能找到更好的抵抗肌萎缩的策略。
类器官芯片实验
将为太空长期驻留提供保障
航天员在太空环境中长期驻留容易出现头晕和睡眠障碍,甚至认知功能改变等神经系统症状,但是空间特殊环境,比如说微重力和辐射等因素到底是如何影响脑功能的?目前具体的机制还不清楚。在这次天舟九号上行中国空间站的科学实验项目中,就有一项空间生命科学领域的实验是围绕这个内容展开的。
这项实验将利用问天舱生物技术实验柜,开展基于类器官芯片的空间特殊环境对人体血脑屏障及脑功能的影响研究。该研究将利用人多能干细胞,在信用卡大小的芯片上构建微型脑类器官模型。这个仿生脑芯片具有丰富的脑微血管网络,神经细胞、免疫细胞以及血脑屏障样结构与功能特征,可以用来模拟人脑的复杂微环境和对外界刺激的响应。

中国科学院大连化学物理研究所研究员秦建华:利用这样的仿生模型,我们可以探究空间环境在细胞、组织、器官等多层次对人脑结构功能的影响和潜在机理,并为航天员在太空中长期驻留作业提供健康风险预测与干预手段。
据介绍,类器官芯片是一种前沿生物技术,也是生命科学领域的新兴研究方向。它通过整合干细胞、类器官与工程学等多种手段,可在体外以前所未有的方式来模拟人体器官的主要结构功能特征,例如大脑、肝脏、肾脏等,为生命科学、疾病研究和药物研发等提供新的技术手段和研究范式。
来源|央视新闻客户端


